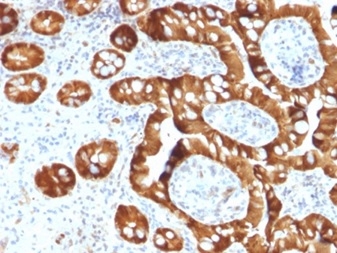

Formalin-fixed, paraffin-embedded human small intestine stained with SULT1E1 Mouse Monoclonal Antibody (CPTC-SULT1E1-1).

Formalin-fixed, paraffin-embedded human lymph node stained with SULT1E1 Mouse Monoclonal Antibody (CPTC-SULT1E1-1).
The soluble sulfotransferases contribute to the elimination of xenobiotics, the activation of procarcinogens and the regulation of hormones by catalyzing the sulfate conjugation of these substances. SULT1E1, also known as STE, is a 294 amino acid member of the SULT1 family. Localized to the cytoplasm and expressed in intestine, liver and kidney, SULT1E1 exists as a homodimer that is thought to control estrogen receptor (ER) levels by sulfurylating free estradiol. Defects in the gene encoding SULT1E1 are associated with an increased risk for endometrial cancer, suggesting a role for SULT1E1 in tumorigenesis.
There are no reviews yet.